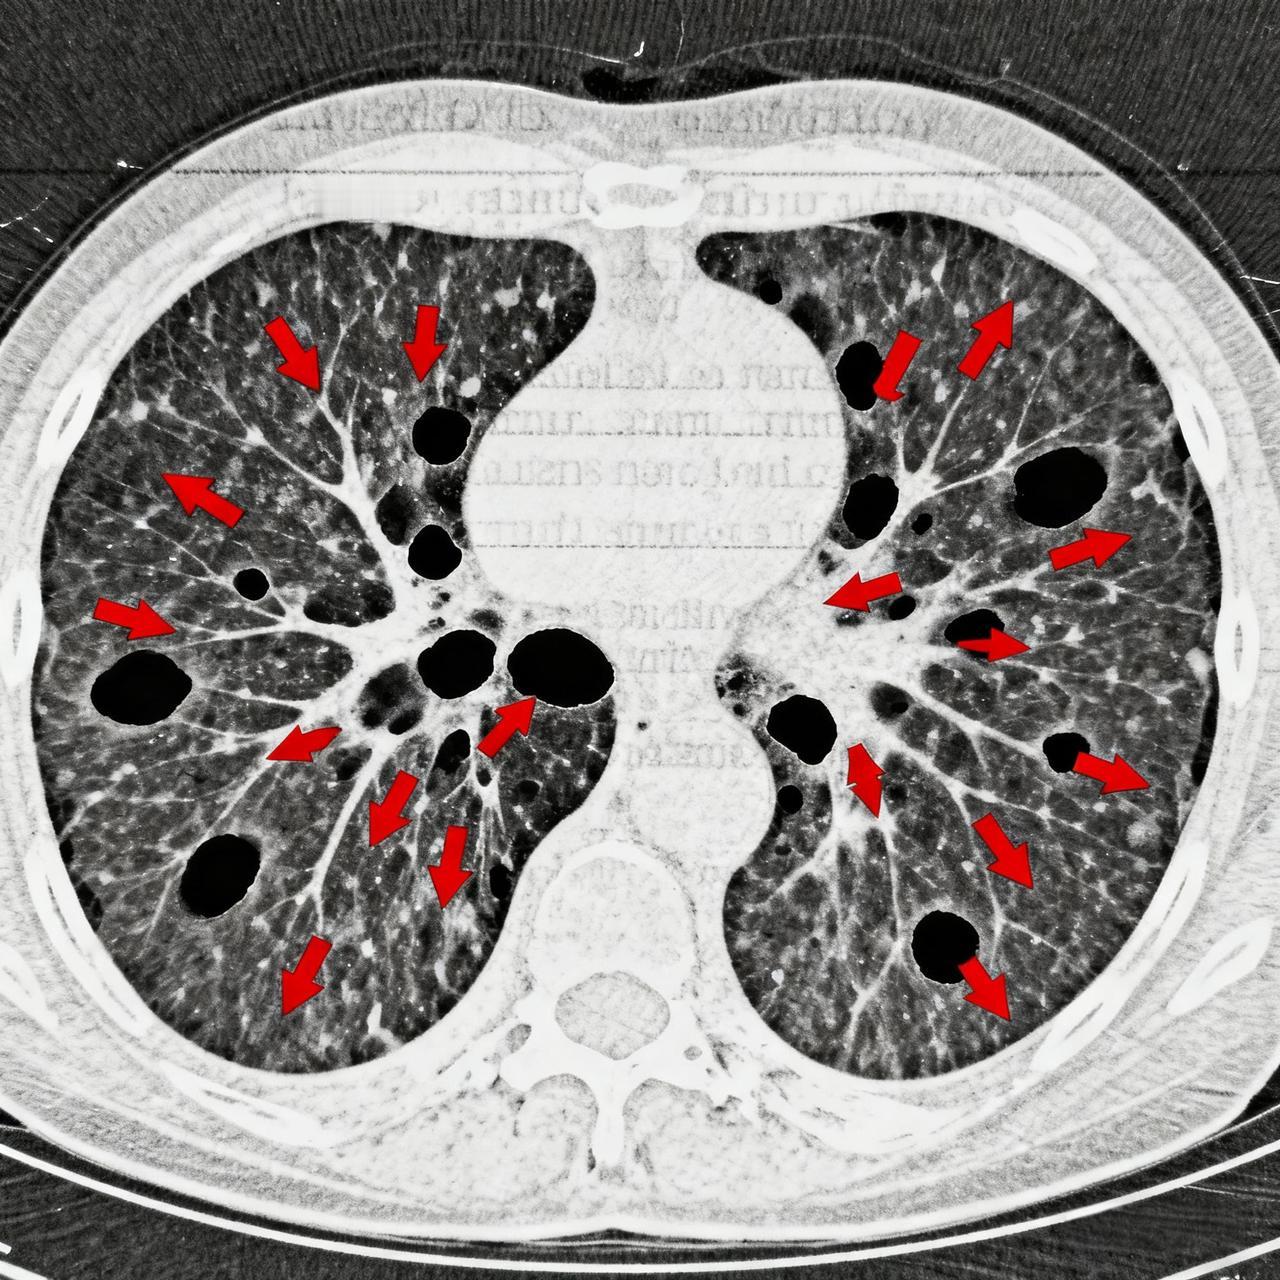

挤颗痘痘肺穿洞?别让“小毛病”拖成大危机 “就挤了颗痘痘,怎么肺就被‘啃’出十余个洞?”20岁大学生小林的遭遇,戳中了无数年轻人的日常——谁没在熬夜爆痘后,忍不住伸手挤掉那颗碍眼的“小疙瘩”?可正是这种习以为常的“手欠”,藏着致命风险。 生活里,我们总爱把身体的小信号当“小事”:痘痘冒了随手挤,咳嗽几声扛一扛,颈椎酸了忍一忍。就像小林,备考熬夜爆痘后没洗手就动手,以为顶多留个痘印,没想到高烧39℃、胸痛到直不起身,CT片上的肺部空洞触目惊心。医生说,鼻根到口角的“危险三角区”血管直通全身,挤痘的细菌可能顺着血液游走,从皮肤感染变成肺部脓肿,甚至危及生命。 快节奏的生活里,我们忙着赶方案、熬通宵,总觉得“小毛病”耗得起。可身体从不会说谎:挤痘引发的感染、久坐熬出的颈椎病、节食饿出的胃病,哪一个不是从“无所谓”开始,慢慢拖成难逆转的问题?你是否也曾在加班时忽略胃痛,在刷手机时无视眼干,在熬夜后对头痛不以为意? 小林的经历不是个例,而是一面镜子。健康从不是“大题小做”,那些被我们忽视的微小不适,可能都是身体发出的求救信号。别等小问题拖成大麻烦才追悔莫及,从今天起,放下挤痘的手、按时吃饭、累了就歇一歇——用心倾听身体的声音,才是对自己最实在的负责。毕竟,没了健康,再光鲜的生活也无从谈起。